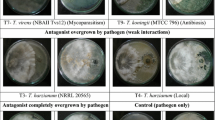

Abstract
Trichoderma is an important antagonist fungi used in biological plant disease management. The present study was carried out to identify the antagonistic efficiency of native Trichoderma isolates against soil born pathogens and to characterize them based on morphological and molecular markers. Twenty-nine Trichoderma cultures were isolated from the agri-horticulture and forest tree rhizosphere. These isolates were identified as T. asperellum, T. aureoviride and T. virens based on the ITS sequences. The isolates produced dark green with or without border (n = 16), light green (n = 9) with white borders and alternate green and white (n = 4) with a flat or uneven appearance. The efficacy of these antagonists was investigated by employing the dual plate confrontation assay technique against fungus causing pigeon pea wilt (Fusarium oxysporum f. sp. udum) and stem rot of tomato (Sclerotium rolfsii). The inhibition zone varied from 46.74 to 100 per cent against F. oxysporum f. sp. udum and the highest inhibition (100%) was exhibited by five T. asperellum isolates. Whereas, the suppression of the Sclerotium was varied from 47.89 to 72.78 per cent. The phylogenetic analysis based on the ITS sequences revealed two distinct clusters, cluster-I (n = 26) and cluster-II (n = 3). To find the diversity, twelve SSR primers were employed and Jaccard’s similarity coefficient was estimated to construct a genetic similarity matrix. The present study has identified five effective native isolates of Trichoderma which can be used against Fusarium and Sclerotium pathogens in the disease management programs.
Similar content being viewed by others
Avoid common mistakes on your manuscript.
Introduction
Plant pathogens reduce the quality and yield of agricultural produce (Savary et al. 2019). In recent years, managing plant pathogens has been shifted from chemical management to eco-friendly biological control (Singh et al. 2012). Biological control involves the suppression of pathogens employing living organisms (Heimpel and Mills 2017). Many biocontrol agents are used in managing plant diseases; the most important are Trichoderma, Pseudomonas, and Bacillus (O’Brien 2017). Among these agents, Trichoderma has gained immense importance as a biological control agent in the agricultural industry due to its varied activities ranging from being an essential antagonist against soil-borne pathogens to acting as a provider of nutrients to the plants as well (Vinale et al. 2008). Trichoderma species are free-living fungi commonly present in soil and root ecosystems and are opportunistic, virulent plant symbionts and parasites on other pathogenic fungi (Harman et al. 2004). Among the Trichoderma species, some are used commercially as effective biocontrol agents viz., T. atroviride, T. harzianum, T. viride, T. hamatum and T. asperellum, which affect the phytopathogens through several mechanisms (Howell 2003; Papavizas 1985; Verma et al. 2007).
The Trichoderma strains compete with fungal pathogens for space and nutrients (Simon and Sivasithamparan 1989), inhibit pathogens by producing extracellular enzymes (Haran et al. 1996) and antifungal antibiotics (Ghisalberti and Rowland 1993), promote plant growth and induce host plant resistance (Inbar et al. 1994; De Meyer et al. 1998). The hydrolytic enzymes partially degrade the cell wall of fungi and lead to mycoparasitism limiting fungal growth and activities (Björkman et al. 1998). Several antagonistic Trichoderma isolates were reported from different places with varied soil types, climate, vegetation and cropping system etc., which influences their effectiveness in disease management (Rai et al. 2016). Therefore, the specific isolates from a particular rhizosphere were isolated and used against the locally distributed pathogens.
Soil-borne diseases are considered a major limitation to crop production (Panth et al. 2020). The pathogens namely, Fusarium, Sclerotium, Verticillium, Phytophthora and Pythium cause 50–75 per cent yield loss in different crops (Mihajlovic et al. 2017). Among these, Fusarium and Sclerotium are important and difficult to manage due to the production of soil born sclerotia and air-borne ascospores (Panth et al. 2020; Smolińska and Kowalska 2018). Fusarium wilt disease in pigeon pea is devastating and causes yield loss of up to 97,000 tonnes per year in India (Saxena et al. 2010). The pathogen is soil and seed-borne, therefore, difficult to manage through fungicide alone. Continuous use of fungicides results in a detrimental effect on the environment and development of resistant strains of the pathogen, health hazards to an applicator as well as to a consumer of the treated material. Their toxic forms persist in soil and contaminate the whole environment (Hemanth et al. 2016).
Sclerotium rolfsii is a soil-borne fungus that causes footrot or collar rot disease, which is a polyphagous and most destructive soil-borne fungus. It has become a major problem and challenging to both farmers and scientists. Owing to its soil-borne nature and wide host range, management through chemicals as well as bio-agents is important (Sahana et al. 2017). Many Trichoderma spp. colonizes the pathogen hyphae, disrupts mycelial growth and kills the organism. For the management of such soil inhabitant pathogenic organisms, biological control offers a novel approach when applied either alone or with other management practices, which cannot be controlled by chemicals alone (Harman 2000; Howell 2003; Manoranjitham et al. 2000).
Like other fungal genera, Trichoderma isolates were defined based on morpho-cultural characteristics (Park et al. 2005; Rifai 1969; Sharma and Singh 2014). However, Trichoderma species are difficult to distinguish morphologically due to variability in species across different geographical locations and hosts (Blaszczyk et al. 2011; Hoyos-Carvajal et al. 2009). The studies also reported overlapping morphological features among species in the genus Trichoderma (Chaverri and Samuels 2013). Therefore, morphological methods are not conclusive, and there is a need for molecular methods such as DNA sequencing and genealogical concordance phylogenetic species recognition using several unliked genes to give accurate identification (Druzhinina et al. 2006). Many molecular techniques are used in recent times, viz., random amplified polymorphic DNA (RAPD), inter simple sequence repeats (ISSR) and amplified fragment length polymorphisms (AFLP) (Muthu Kumar and Sharma 2011; Shahid et al. 2013; Shalini Devi et al. 2012) to study the genetic variability of the organisms. However, the dominant nature of such markers limits their use in comparative studies (Rai et al. 2016). The use of simple sequence repeat (SSR) markers has gained potential importance in comparative studies since the SSR markers are reproducible, multiallelic, co-dominant, relatively abundant, and have good coverage of the genome (Rai et al. 2016; Singh et al. 2014).
Trichoderma spp. isolated from the different crop rhizosphere need to be evaluated against different soil-borne pathogens. By considering these factors, in the present investigation, we have isolated Trichoderma spp. from different agricultural and horticultural crop rhizosphere soils, including forest trees and identified them based on their morphological and ITS sequencing and evaluated their antagonistic nature against F. oxysporum f.sp. udum and S. rolfsi. Further, the diversity of isolates was also analyzed by employing the SSR markers. The present study has contributed in identifying the effective antagonistic Trichoderma species and also in understanding the native species diversity in the different crop rhizosphere soils of Karnataka, India, which can be used effectively in integrated plant disease management.
Material and methods
Sampling and isolation of Trichoderma isolates
Trichoderma species were isolated from soil samples collected from rhizospheres of banana (n = 7), pigeon pea (n = 6), arecanut (n = 6), pongamia (n = 5), teak (n = 4) and tomato (n = 1) during an exploratory survey carried at Karnataka, India (Table 1). The antagonists were isolated by serial dilution technique on Potato Dextrose Agar (PDA) and were maintained initially on PDA at 25 ± 1 °C for seven days. After an incubation period, colonies were transferred and purified on Trichoderma specific media (TSM) (Elad and Chet 1983) which were further confirmed through Trichoderma morphological keys and molecular techniques.
Isolation of Fusarium oxysporum f. sp. udum and Sclerotium rolfsii
The pigeon pea crop showing typical symptoms of the wilt (caused by Fusarium oxysporum f. sp. udum) was collected and the symptomatic part was cut into small pieces. The pieces were surface sterilized in sodium hypochlorite (1%) solution for one minute and washed thrice using sterilized distilled water and aseptically transferred on PDA. The plates were incubated at room temperature (27 ± 1 °C) for seven days to facilitate the growth of the fungus. The pathogen was identified morphologically by mycelia and conidial character (Booth 1971).
The tomato plants with symptoms of stem rot (caused by S. rolfsii) were collected and isolated using a similar technique as described for F. oxysporum. The pathogen was morphologically identified based on mycelia and sclerotial characters (Farr et al. 1995). A pathogenicity test for both the isolated organisms was performed as described previously (Ravikumara et al. 2022; Xie et al. 2014).
Morphological characterization of Trichoderma isolates
Morphological identification was accomplished through morphological keys (Bissett et al. 2015; Rifai 1969; Samuels et al. 2012), considering macroscopic characteristics like colour and texture of the colony surface and reverse, presence or absence of pigmentation, a pattern of growth and sporulation. A loopful mycelium of each isolate was dyed with cotton blue to visualize and analyse the microscopic characters according to morphology, size, disposition of the conidia and the phialides with a Lawrence and Mayo microscope with scope image 9.0 (X3). The size of the conidiophores and conidia were recorded while microscopic observation of each isolates and statistically analysed.
Multivariate analysis was done to understand the role of each morphological trait in diversity. The factors number was selected based on roots number larger than 1, and the number of primary variables used in the factor analysis was equal to 8.
Fungal confrontation assay
Antagonistic activity of Trichoderma isolates was evaluated in vitro against two soil-borne pathogenic fungi viz., F. oxysporum f. sp. udum and S. rolfsii by dual culture technique according to Morton and Strouble (1955). The inhibition of pathogen growth was calculated by using the formula given by Vincent (1947).
Molecular characterization of Trichoderma isolates
Extraction of genomic DNA
Total genomic DNA of Trichoderma species was extracted by CTAB (Cetyl-trimethyl ammonium bromide) method (Rogers and Bendich 1994). Single-spore isolates of Trichoderma were cultured in Borosil conical flasks (250 ml) containing 100 ml of potato dextrose broth at 25 ± 1 °C for seven days. The mycelia were harvested by filtration through Whatman filter paper and dried with sterilized blotting paper. The dried mycelia were used immediately for DNA extraction. Samples were frozen in liquid nitrogen and grounded in mortar and pestle to a fine powder and preserved at – 20 ℃ for further studies (Shahid et al. 2014). The quantity of DNA was estimated by Qubit™ 4.0 Fluorometer (ThermoFisher Scientific, USA).
PCR amplification
ITS-1F and ITS-4 (White et al. 1990; Gardes and Bruns 1993), and ten SSR primers (Mohammad et al. 2013) were selected for amplification of the Trichoderma isolates (Table 2). PCR amplification was performed by mixing 50 ng of the template DNA with 0.2 mM concentrations of each primer, 200 mM concentrations of each dNTP, and 2.5 U of Taq DNA polymerase in Taq Buffer (100 mM Tris–HCl, pH 8.3; 500 mM KCl) and volume was made to 25 μl using Millipore water. The PCR reaction was performed with initial denaturation for 5 min at 94 °C, followed by denaturation, annealing and extension for 60 s at 94 °C, 60 s at 55 °C, and 3 min at 72 °C, respectively of 30 cycles and with a final extension of 5 min at 72 °C in an ABS-VeritiTM 96-well thermocycler (Applied Biosystems, USA). In the case of SSR primers, the reaction condition was similar to ITS but performed for 35 cycles.
Analysis of PCR products
To verify the efficiency of the PCR reaction, 4 μl of the obtained products were analyzed by 1.2% gel electrophoresis in 0.5 × TAE buffer (40 mM Tris base, 20 mM acetic acid, 1 mM EDTA solution with pH 8) and stained with ethidium bromide. Electrophoresis was conducted at 75 V for 40 min. After the run, the gels were visualized under an ultraviolet transilluminator to confirm the amplification.
Sequencing and phylogenetic analysis
The PCR products of ITS were purified using HiPura® PCR Product Purification Kit (HiMediaTM Laboratories Pvt Ltd, Mumbai, India). The sequencing of ITS PCR amplified products of 29 isolates was carried out using a commercial facility (Agri Genome Labs, Kerala, India). The sequencing was done using ITS-1 and ITS-4 primers, and sequences obtained were checked and edited in BioEdit 2.0 software (Version 7.2.5) (Hall 1999). Subsequently, the concurrent sequences obtained were compared with the GenBank database using the basic local alignment search tool (BLAST) algorithm (http://www.ncbi.nlm.nih.gov). Sequences were deposited in GenBank, and accession numbers were obtained for all the isolates (Table 1). The isolates (n = 29) belonging to the Trichoderma species from the study and T. viride (strain ATCC 28038), retrieved from the GeneBank database (out grouping), were used to construct the phylogenetic tree. The phylogeny was inferred by comparing the region of ITS phylogenetic groupings by analysing Maximum Likelihood Estimates (MLE) on Mega X software (Kumar et al. 2018) and estimated with a bootstrap value of 1000 pseudoreplicates. Sequences were blasted on BLASTn, and those with a high score (1000) and e-value equal to zero were used for comparison.
Scoring of bands and data analysis
The image of the gel electrophoresis was documented through the Bio-system 1D gel documentation system. All polymorphic bands were scored and analysed. Polymorphic information content (PIC) values were calculated according to Anderson et al. (1993) for each SSR locus. PIC values were determined using Power marker Version 3.25 (Liu and Muse 2005). The binary data (1 or 0) was generated for each marker based on the presence or absence of bands. Jaccard’s similarity coefficient and a dendrogram were constructed based on unweighted pair group methods (UPGMA) and analyzed by numerical taxonomy system (NTSYS) statistical package version 2.2 (Rohlf 1998).
Results
Morphological characterization of Trichoderma isolates
Among 29 Trichoderma isolates, 16 isolates showed morphological colonies as dark green; nine isolates were exhibited light green with white colour borders and four isolates represented colony pattern as an alternate green and white colour with a flat appearance (Fig. 1A). In contrast, most isolates were light green on reverse visualization, but some isolates exhibited reverse colony as white to dark green colour (Table 3). Most isolates possessed uneven mycelial form and produced one to five concentric rings. Morphometry of all isolates indicated that the conidiophore was hyaline, narrow and branched and the conidial shape varied from oval to round and ellipsoid (Table 3). The spore colour varied from olive green to green, and the length of conidia varied from 5.7 to7.23 μm. Based on the morphological characters, the isolates were classified into three morpho-groups (MG) (Table 4). The MG-1 consist of 16 isolates followed by MG-2 with 9 and MG-3 with 4 isolates, respectively.
Morphological characterization of Trichoderma isolates. A The morphological variability of 29 isolates as exhibited on PDA. B Bi-axis plot representing the distribution of isolates based on estimated morphological variables. The isolates were distributed in all the directions of the plots evidencing higher variability and diversity. C Dendrogram derived from the cluster analysis (UPGMA) shows the relationship among Trichoderma isolates based on morphological traits
In the factorial analysis employing major factors analysis and based on specific numbers greater than 1, five factors were identified, and they all together justified 78.68 per cent of existing variations among the morphological traits (Table 5). The 5th factor (possessing 76.68% of the variance among traits) played an essential role in justifying morphological variation changes. A Bi-axis plot was created based on phenotypic correlation and dissimilarity between morphological traits. Bi-axis screen plot (Fig. 1B) analysis indicated the importance of each factor in distributing all the Trichoderma isolates among the axis. The isolates were distributed in all the directions of the plots evidencing higher variability and diversity among them. Cluster analysis of 29 isolates of Trichoderma on an average of eight morphological parameters was performed (Fig. 1C) and three main clusters were distinguished. The first cluster consists of two isolates, followed by the second cluster with 12 isolates and the third cluster with 15 isolates.
In-vitro confrontation assay of Trichoderma isolates
The antagonistic potential of 29 Trichoderma isolates was evaluated against F. oxysporum f. sp. udum and S. rolfsii by dual culture technique (Table 1; Fig. 2A and B). The inhibition zone varied from 46.74 to 100 per cent against F. oxysporum f. sp. udum (Fig. 2C). The highest inhibition (100%) was observed in five T. asperellum isolates viz., Tr-10, Tr-21 (banana rhizosphere), Tr-17 (pongamia rhizosphere), Tr-19 (teak rhizosphere), and Tr-25 (pigeon pea rhizosphere) and least inhibition (46.74%) was recorded by T. asperellum Tr-8 isolate (arecanut rhizosphere). Whereas against S. rolfsii, the zone of inhibition varied from 47.89 to 72.78 per cent (Fig. 2C). The highest inhibition (72.78%) was observed in T. asperellum Tr-1 isolate (teak rhizosphere) and the least (47.89%) in T. asperellum Tr-24 isolate (pigeon pea rhizosphere).
Dual confrontation assay to evaluate the antagonistic effect of Trichoderma isolates against soil born pathogens. Trichoderma isolates were grown on PDA and placed against the pathogens namely A Fusarium oxysporum f.sp. udum and, B Sclerotium rolfsii. C The Box Plot analysis was used to express the efficacy of the isolates against pathogens
Molecular characterization using ITS sequences
Genomic DNA subjected to PCR using ITS-1 and ITS-4 yielded ~ 600 bp products which were confirmed on 0.5 per cent agarose by gel electrophoresis. PCR products of amplified ITS regions were Sanger sequenced using ITS-1 and ITS-4 primers from both directions (Table 1). The BLAST program was used to determine the species identity of Trichoderma isolates and found that the Tr-14 isolate was identified as T. virens, the Tr-22 isolate was identified as T. aureoviride, whereas the remaining isolates were identified as T. asperellum. The sequences obtained were deposited in the NCBI GenBank database (Table 1).
The evolutionary analysis of the ITS sequence of 29 isolates of Karnataka revealed two distinct clusters, cluster-I and cluster-II (Fig. 3). The majority of the isolates (n = 26) were clustered together in cluster I, whereas only three T. asperellum, viz., Tr 13, Tr 23 and Tr 28, were diverged separately into cluster II. Within cluster-I, the 17 isolates were grouped under cluster-IA, whereas 9 isolates were grouped under cluster IB. The cluster IA consists predominantly of T. asperellum (n = 15), followed by T. aureoviridae (n = 1), and T. virens (n = 1). The isolates from different rhizospheric soils were distributed across the tree, showing no correlation between the crop type and native Trichoderma species. The outgroup AY3800909.1 (T. viride strain ATCC 28038) was grouped in cluster II along with the T. asperellum isolates.
Phylogenetic tree based on ITS sequences. The evolutionary history was inferred using the Maximum Composite Likelihood method. The optimal tree with the sum of branch length = 41.35094847 is shown. This analysis involved 30 nucleotide sequences. All ambiguous positions were removed for each sequence pair (pairwise deletion option). There were a total of 647 positions in the final dataset
Diversity analysis using SSR primers
Ten simple sequence repeats (SSR) primers were used in which four were amplified (Fig. 4A). Polymorphism information content (PIC) values for four SSR primers were recorded and PIC values ranged from 0.50 to 0.39. The highest PIC value (0.50) was obtained for SSR 18, followed by SSR 13 (0.48) and SSR 6 (0.40). The lowest PIC value (0.39) was obtained for SSR 10. PIC value revealed that SSR 18 was a better marker to study isolates. Genotyping data generated by 29 Trichoderma isolates with four SSR primers were subjected to the estimation of Jaccard's similarity coefficient and the construction of a genetic similarity matrix. The UPGMA clustering system-generated ten genetic clusters with a similarity coefficient of 52.00 per cent (Fig. 4B). Cluster eight was the most significant with eight Trichoderma isolates, followed by clusters four and one with six, clusters six and seven with three isolates, cluster three with two isolates and clusters two, five, nine and ten with one isolate, respectively. The highest genetic distance was observed between the farthest clusters.
Discussion
The genus Trichoderma has paved immense significance due to its antagonistic nature against several plant pathogens (Panth et al. 2020). To develop and utilize an efficient fungal antagonist, the identification and characterization of Trichoderma is a prerequisite.
The morphological characteristics of Trichoderma concerning mycelia and spore production were studied on PDA since the mycelial development and pigmentation can be observed best on PDA than in other media (Samuels et al. 2002). Many workers reported green or yellow-green colonies (Kumar et al. 2014; Samuels et al. 2002). Initially, colonies appeared as a cream which later turned to dark green colour. Srivastava et al. (2014) reported that the colony colour changes from a light green shade to dull green with conidia production. The formation of conidia results in the blue-green to yellow-green pigmentation of the colony (Siddiquee 2017). Concentric rings can be observed occasionally for some species of Trichoderma (Samuels et al. 2002). The length and breadth of the conidia varied from 5.70 to 7.23 μm and 4.71 to 6.29 μm respectively. The total size of conidia varied from 29.30 to 44.73 μm. The results obtained were more or less similar to observations made by Soesanto et al. (2011), where the average size of conidia was 5 μm in length and 2 μm in width of Trichoderma isolate 3, and 7.20 × 7.20 μm in Trichoderma isolate 5. These results were also supported by Kumar et al. (2010) who reported 2.50–3.50 × 4.00–5.50 μm as the length and breadth of conidia.
To identify the efficient indigenous isolate of Trichoderma with prominent antagonist activity, isolates were subjected to a dual culture study. All the Trichoderma isolates inhibited the colony growth of F. oxysporum f. sp. udum and S. rolfsii. The earlier studies also reported the significant inhibition of the mycelial growth in the pathogenic strains of F. oxysporum (Athul and Jisha 2014; Altinok and Erdogan 2015; Kamala and Indira Devi 2012; Ramezani 2010; Sundaramoorthy and Balabaskar 2013) and S. rolfsii (Athul and Jisha 2014; Rekha et al. 2012).
The morphological study alone is insufficient to identify the Trichoderma spp. precisely due to the availability of limited variation within isolates that may overlap and leads to misidentification of the species (Anees et al. 2010). The expression of the morphological characters was also influenced by the kind of media used and the prevailing temperature (Hassan et al. 2014). Based on ITS sequencing of 29 isolates, 27 were identified as T. asperellum, one as T. virens and T. aureo viride. Identification of Trichoderma by using universal primers (ITS-1 and ITS-4) was also made by Mohammad et al. (2013) and Mohammad et al. (2014). Four SSR loci were employed to find the genetic diversity of 29 isolates of Trichoderma spp. PIC value is a reflection of frequency and allele diversity among isolates. PIC values ranged from 0.50 to 0.39 which was similar to Rai et al. (2016), who reported PIC values > 0.40. Shahid et al (2013) evaluated the variability among Trichoderma isolates by using SSR and RAPD markers and obtained the highest polymorphism (> 77%) with SSR followed by RAPD (~ 50%).
In conclusion, the present study has identified the effective Trichoderma isolates from different crop rhizosphere for the management of soil-born plant diseases, especially against Fusarium oxysporum f. sp. udum and Sclerotium rolfsii. The rhizosphere of one crop contained the Trichoderma that was also effective against the pathogen from another rhizosphere and thereby providing an opportunity to use Trichoderma from any rhizosphere to contain the plant pathogen of any crop. The study identified the presence of T. virens, T. aureoviride, and T. asperellum in different crop rhizosphere and T. asperellum as predominant Trichoderma species in the soils of the present study.
Availability of data and material
The data relating to the ITS sequences are available at NCBI GenBank.
Code availability
Not Applicable.
References
Altinok HH, Erdogan O (2015) Determination of the in vitro effect of Trichoderma harzianum on phytopathogenic strains of Fusarium oxysporum. Not Bot Horti Agrobo 43(2):494–500
Anderson JA, Churchill GA, Autrique JE, Tanksley SD, Sorrells ME (1993) Optimizing parental selection for genetic linkage maps. Genome 36:181–186
Anees M, Tronsmo A, Hermann V, Hjeljord LG, Heraud C, Steinberg C (2010) Characterization of field strains of Trichoderma antagonistic against Rhizoctonia solani. Fungal Biol 114:691–701
Athul SR, Jisha MS (2014) Screening and identification of potential Trichoderma spp. against soil-borne pathogens of vanilla (Vanilla planiolia). Indian J Agric Res 48(6):459–464
Bissett J, Gams W, Jaklitsch W, Samuels GJ (2015) Accepted Trichoderma names in the year 2015. IMA Fungus 6:263–295
Björkman T, Blanchard LM, Harman GE (1998) Growth enhancement of shrunken-2 (sh2) sweet corn by Trichoderma harzianum 1295–22: effect of environmental stress. J Am Soc Hortic 123:35–40
Blaszczyk L, Popiel D, Chełkowski J, Koczyk G, Samuels GJ, Sobieralski K, Siwulski M (2011) Species diversity of Trichoderma in Poland. J Appl Genet 52:233–243
Booth C (1971) The genus Fusarium. Commonwealth Mycological Institute, Kew, Surrey, pp 114
Chaverri P, Samuels GJ (2013) Evolution of habitat preference and nutrition mode in a cosmopolitan fungal genus with evidence of interkingdom host jumps and major shifts in ecology. Evolution 67:2823–2837
De Meyer G, Bigirimana J, Elad Y, Hofte M (1998) Induced systemic resistance in Trichoderma harzianum T39 biocontrol of Botrytis cinerea. Eur J Plant Pathol 104:279–286
Druzhinina IS, Kopchinskiy AG, Kubicek CP (2006) The first 100 Trichoderma species characterized by molecular data. Mycoscience 47:55
Elad Y, Chet I (1983) Improved selective media for isolation of Trichoderma spp. or Fusarium spp. Phytoparasitica 11(1):55
Farr DF, Bills GF, Chamuris GP, Rossman AY (1995) Fungi on plants and plant products in the United States. APS Press, London, pp 526–528
Gardes M, Bruns TD (1993) ITS primers with enhanced specificity for basidiomycetes-application to the identification of mycorrhizae and rusts. Mol Ecol 2(2):113–118
Ghisalberti EL, Rowland GY (1993) Antifungal metabolites from Trichoderma harzianum. J Nat Prod 56:1799–1804
Hall TA (1999) BioEdit: a user-friendly biological sequence alignment editor and analysis program for Windows 95/98/NT. Nucleic Acids Symp Ser 41:95–98
Haran S, Schickler H, Chet I (1996) Molecular mechanisms of lytic enzymes involved in the biocontrol activity of Trichoderma harzianum. Microbiology 142:2321–2331
Harman GE (2000) Myths and Dogmas of biocontrol changes in perception derived from research on Trichoderma harzianum T22. Pl Dis 84:377–393
Harman GE, Howell CR, Viterbo A, Chet I, Lorito M (2004) Trichoderma species-opportunistic, avirulent plant symbionts. Nat Rev Microbiol 2(1):43–56
Hassan MM, Gaber A, El-Hallous EI (2014) Molecular and morphological characterization of Trichoderma harzianum from different Egyptian soils. Wulfenia J 21:80–96
Heimpel GE, Mills NJ (2017) Biological control. Cambridge University Press, Cambridge
Hemanth G, Kumar PKR, Niharika SP, Samuel KK (2016) Fungicides effect on soil microflora in Tekkali Mandal, Srikakulam (Dist). Int J Res Dev Pharm L Sci 5(4):2245–2250
Howell CR (2003) Mechanisms employed by Trichoderma species in the biological control of plant diseases: the history and evolution of current concepts. Plant Dis 87(1):4–10
Hoyos-Carvajal L, Orduz S, Bissett J (2009) Growth stimulation in beans (Phaseolus vulgaris L.) by Trichoderma. Biol Control 51:409–416
Inbar J, Abramshy D, Cohen D, Chet I (1994) Plant growth enhancement and disease control by Trichoderma harzianum in vegetable seedlings grown under commercial conditions. Eur J Plant Pathol 100:337–346
Kamala TH, Indira Devi S (2012) Biocontrol properties of indigenous Trichoderma isolates from North-east India against Fusarium oxysporum and Rhizoctonia solani. Afr J Biotechnol 11(34):8491–8499
Kumar K, Amaresan N, Someshwar B, Madhuri K, Srivastava RC (2010) Unreported species of Trichoderma isolated from tropical regions of Andaman and Nicobar islands in India. J Mycol Pl Pathol 40(3):314–321
Kumar A, Sahu TK, Bhalla A, Jain AK (2014) Morphological characterization of Trichoderma harzianum from Madhya Pradesh. Ann Plant Protect Sci 22(1):228–229
Kumar S, Stecher G, Li M, Knyaz C, Tamura K (2018) MEGA X: molecular evolutionary genetics analysis across computing platforms. Mol Biol Evol Bio 35:1547–1549
Liu K, Muse SV (2005) Power Marker: an integrated analysis environment for genetic marker analysis. Bioinformatics 21(9):2128–2129
Manoranjitham SK, Prakasam V, Rajappan K, Amutha G (2000) Effect of two antagonists on damping-off disease of tomato. Indian Phytopathol 53(4):441–443
Mihajlovic M, Rekanovic E, Hrustic J, Tanovic B (2017) Methods for management of soilborne plant pathogens. Pestic Fitomed 32:9–24
Mohammad S, Mukesh S, Antima S, Vipul K, Sonika P, Anuradha S (2013) Morphological, molecular identification and SSR marker analysis of a potential strain of Trichoderma/Hypocrea for production of a bioformulation. J Pl Pathol Microb 4(10):1–7
Mohammad S, Mukesh S, Vipul K, Anuradha S, Antima S, Sonika P, Smita R, Neelam P, Srivastava AK (2014) Phylogenetic diversity analysis of Trichoderma species based on internal transcribed spacer (ITS) marker. Afr J Microbiol Res 13(3):449–455
Morton DT, Strouble NH (1955) Antagonistic and stimulatory effects of microorganism upon Sclerotium rolfsii. Phytopathology 45:419–420
Muthu Kumar A, Sharma P (2011) Molecular and morphological characters: an appurtenance for antagonism in Trichoderma spp. Afr J Biotechnol 10:4532–4543
O’Brien PA (2017) Biological control of plant diseases. Australas Plant Pathol 46(4):293–304
Panth M, Hassler SC, Baysal-Gurel F (2020) Methods for management of soil borne diseases in crop production. Agriculture 10(1):16
Papavizas GC (1985) Trichoderma and Gliocladium: biology, ecology, and potential for biocontrol. Annu Rev Phytopathol 23(1):23–54
Park MS, Seo GS, Bae KS, Yu SH (2005) Characterization of Trichoderma spp. associated with green mold of oyster mushroom by PCR-RFLP and sequence analysis of ITS regions of rDNA. Plant Pathol J 21(3):229–236
Rai S, Kashyap PL, Kumar S, Srivastava AK, Ramteke PW (2016) Comparative analysis of microsatellites in five different antagonistic Trichoderma species for diversity assessment. World J Microbiol Biotechnol 32(1):8
Ramezani H (2010) Antagonistic effects of Trichoderma spp. against Fusarium oxysporum f. sp. Lycopersici causal agent of tomato wilt. Pl Protec J 2(1):167–173
Ravikumar BM, Ramanagouda G, Naik MK et al (2022) Distribution and pathogenic diversity in Fusarium udum Butler isolates: the causal agent of pigeon pea Fusarium wilt. BMC Plant Biol 22:147. https://doi.org/10.1186/s12870-022-03526-8
Rekha D, Patil MB, Shridhar SP, Swamy KM, Rajini BG (2012) In vitro screening of native Trichoderma isolates against Sclerotium rolfsii causing collar rot of ground nut. Int J Sci Nat 3(1):117–120
Rifai MA (1969) A revision of the genus Trichoderma. Mycol Pap 116:1–56
Rogers SO, Bendich AJ (1994) Extraction of total cellular DNA from plants, algae and fungi. In: Plant molecular biology manual Springer, Dordrecht, pp 183–190
Rohlf FJ (1998) NTSyS-p.c. Numerical taxonomy and multivariate analysis system (Version 2.0). Exeter Software Publishers Ltd., Setauket
Sahana NB, Sanath Kumar VB, Thejesha AG (2017) In vitro evaluation of bio-agents and fungicides against foot rot pathogen (Sclerotium rolfsii Sacc.) of tomato. Int J Curr Microbiol Appl Sci 6(3):1591–1598
Samuels GJ, Dodd SL, Gams W, Castlebury LA, Petrini O (2002) Trichoderma species associated with the green mold epidemic of commercially grown Agaricus bisporus. Mycologia 94:146–170
Samuels GJ, Ismaiel A, Mulaw TB, Szakacs G, Druzhinina IS, Kubicek CP et al (2012) The Longibrachiatum Clade of Trichoderma: a revision with new species. Fungal Divers 5591:77–108
Savary S, Willocquet L, Pethybridge SJ et al (2019) The global burden of pathogens and pests on major food crops. Nat Ecol Evol 3:430–439. https://doi.org/10.1038/s41559-018-0793-y
Saxena RK, Saxena KB, Kumar RV, Hoisington DA, Varshney RK (2010) Simple sequence repeat-based diversity in elite pigeon pea genotypes for developing mapping populations to map resistance to Fusarium wilt and sterility mosaic disease. J Pl Breed 129:135–141
Shahid M, Srivastava M, Sharma A, Kumar V, Pandey S, Singh A (2013) Morphological, molecular identification and SSR marker analysis of a potential strain of Trichoderma/hypocrea for production of a bioformulation. J Plant Pathol Microbiol 4:204
Shahid M, Srivastava M, Kumar V, Singh A, Sharma A, Pandey S, Rastogi S, Pathak N, Srivastava AK (2014) Phylogenetic diversity analysis of Trichoderma species based on internal transcribed spacer (ITS) marker. Afr J Biotechnol 13:3. https://doi.org/10.5897/AJB2013.13075
Shalini Devi S, Sreenivasulu Y, Saritha S, Ram Kumar M, Praveen Kumar K, Sudhakar P (2012) Molecular diversity of native Trichoderma isolates against Fusarium oxysporum f. sp. lycopersici (Sacc.). A casual agent of Fusarium wilt in tomato (Lycopersicon esculentum Mill.). Arch Phytopathol Plant Prot 45:686–698
Sharma KK, Singh US (2014) Cultural and morphological characterization of rhizospheric isolates of fungal antagonist Trichoderma. J Appl Natl Sci 6(2):451–456
Siddiquee S (2017) Morphology-based characterization of Trichoderma species. In: Practical handbook of the biology and molecular diversity of Trichoderma species from tropical regions. Springer, Cham, pp 41–73
Simon A, Sivasithamparan K (1989) Pathogen suppression: a case study of Gaeumannomyces graminis var. tritici in soil. Soil Biol Biochem 21:331–337
Singh AK, Bhatt BP, Singh D, Gade RM, Singh AK, Sangle UR (2012) Good Agronomic Practices (GAP)-An efficient and eco-friendly tool for sustainable management of plant diseases under changing climate scenario. J Plant Dis Sci 7(1):1–8
Singh R, Kumar S, Kashyap PL, Srivastava AK, Mishra S, Sharma AK (2014) Identification and characterization of microsatellite from Alternaria brassicicola to assess cross-species transferability and utility as a diagnostic marker. Mol Biotechnol 56:1049–1059
Smolińska U, Kowalska B (2018) Biological control of the soil-borne fungal pathogen Sclerotinia sclerotiorum––a review. J Plant Pathol 100(1):1–12
Soesanto L, Utami DS, Rahayuniati RF (2011) Morphological characteristics of four Trichoderma isolates and two endophytic Fusarium isolates. Can J Sci Indus Res 2(8):294–306
Srivastava M, Shahid M, Pandey S, Singh A, Kumar V, Gupta S, Maurya M (2014) Trichoderma genome to genomics: a review. J Data Min Genomics Proteomics 5(162):2153–2602
Sundaramoorthy S, Balabaskar P (2013) Biocontrol efficacy of Trichoderma spp. against wilt of tomato caused by Fusarium oxysporum f. sp. lycopersici. J Appl Biol Biotechnol 1(3):36–40
Verma M, Brar SK, Tyagi RD, Surampalli RY, Valero JR (2007) Antagonistic fungi, Trichoderma spp.: panoply of biological control. Biochem Eng J 37(1):1–20
Vinale F, Sivasithamparam K, Ghisalberti EL, Marra R, Woo SL, Lorito M (2008) Trichoderma–plant-pathogen interactions. Soil Biol Biochem 40(1):1–10
Vincent JM (1947) Distortion of fungal hyphae in the presence of certain inhibitors. Nature 150:850
White TJ, Bruns T, Lee S, Taylor J (1990) Amplification and direct sequencing of fungal ribosomal RNA genes for phylogenetics. In: Innis MA, Gelfand DH, Sninsky JJ, White TJ (eds) PCR protocols. A guide to methods and applications. Academic Press, San Diego, pp 315–322
Xie C, Huang CH, Vallad GE (2014) Mycelial compatibility and pathogenic diversity among Sclerotium rolfsii isolates in the southern United States. Plant Dis 98(12):1685–1694
Funding
The present investigation was funded by the University of Agricultural and Horticultural Sciences, Shivamogga, Karnataka, India.
Author information
Authors and Affiliations
Corresponding author
Ethics declarations
Conflicts of interest
Not Applicable.
Ethics approval
Not Applicable.
Consent to participate
Not Applicable.
Consent for publication
Not Applicable.
Additional information
Publisher's Note
Springer Nature remains neutral with regard to jurisdictional claims in published maps and institutional affiliations.
Rights and permissions
About this article
Cite this article
Maheshwary, N.P., Naik, B.G., Chittaragi, A. et al. Morpho-molecular characterization, diversity analysis and antagonistic activity of Trichoderma isolates against predominant soil born pathogens. Indian Phytopathology 75, 1009–1020 (2022). https://doi.org/10.1007/s42360-022-00528-2
Received:
Revised:
Accepted:
Published:
Issue Date:
DOI: https://doi.org/10.1007/s42360-022-00528-2